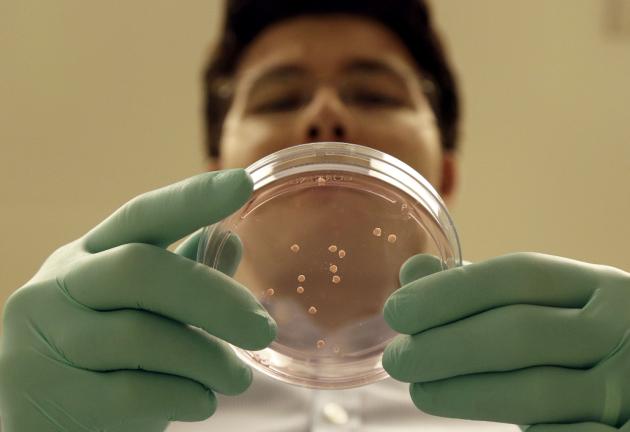
Cultivan partes de cerebro humano para estudios
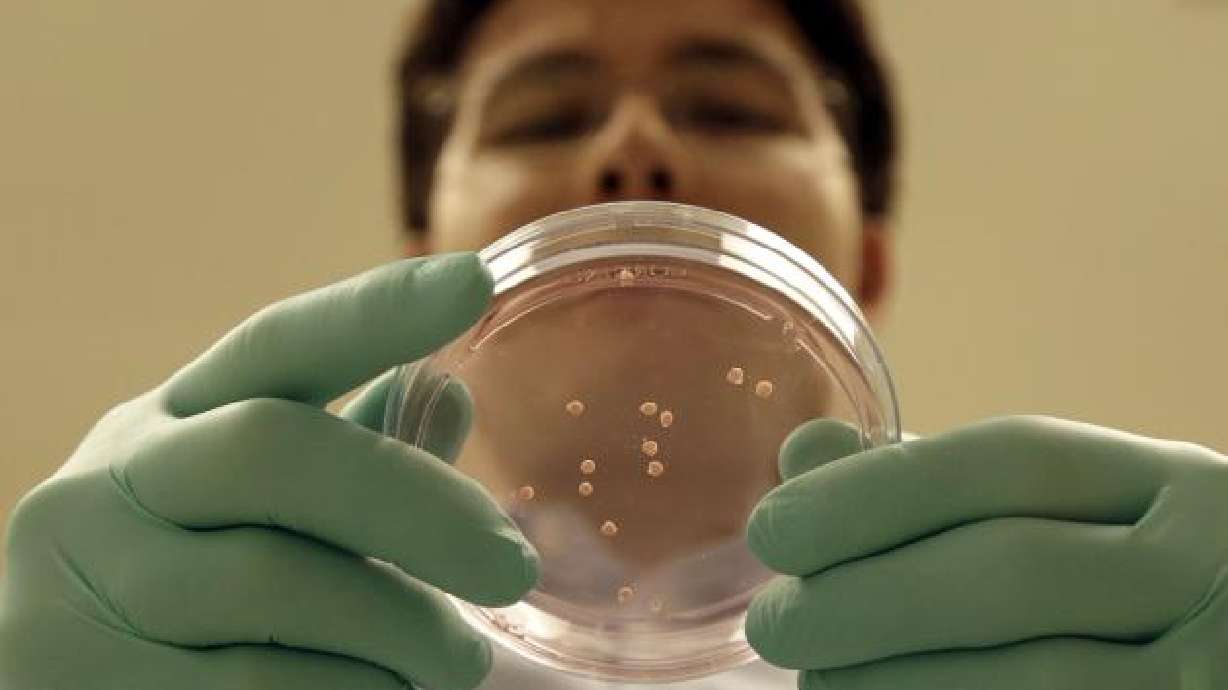
Cultivan partes de cerebro humano para estudios

Estimated read time: 2-3 minutes
This archived news story is available only for your personal, non-commercial use. Information in the story may be outdated or superseded by additional information. Reading or replaying the story in its archived form does not constitute a republication of the story.
El neurobiólogo Sergiu Pasca solía envidiar a los especialistas en cáncer, pues ellos podían utilizar tumores en sus estudios, mientras que Pasca no podía estudiar directamente cerebros vivos.
Pero en estos días, Pasca no está tan lejos.
En su laboratorio en la Universidad Stanford, miles de bolitas de tejido cerebral humano flotan en placas de Petri. Fueron creadas a partir de células cerebrales cutáneas humanas, incluyendo algunas de personas con autismo. Cada una tiene el ADN de la persona de la que provino, y cada una se organizó lo suficiente para formar parte del cerebro que interesa a Pasca.
Él no es el único. Decenas de laboratorios están cultivando tejido cerebral humano para estudiarlo, una práctica que atrajo atención en el 2013 cuando científicos dijeron que habían creado "mini cerebros" que contenían partes importantes del órgano fetal.
Dejémoslo claro: Aunque las células cerebrales en el tejido cultivado en los laboratorios muestran actividad, nadie ha creado un cerebro humano adulto completamente funcional.
Las versiones reportadas en revistas científicas reproducen una o más partes del cerebro fetal. (Un anuncio en agosto de un cerebro casi completo comparable con uno fetal no ha sido corroborado aún por ningún artículo en una revista científica y expertos se han abstenido de comentar hasta poder ver los detalles).
Científicos dicen que la tecnología tiene gran potencial para estudiar las raíces de padecimientos como autismo y esquizofrenia, probar posibles tratamientos y lidiar con interrogantes básicas sobre la evolución.
Es parte de un movimiento más vasto en años recientes para crear "organoides", versiones en miniatura de órganos o partes claves de órganos humanos. Entre los objetivos están el estudio de enfermedades, realizar pruebas con posibles tratamientos y quizás suministrar remplazos para trasplantes. Científicos han producido organoides representando el intestino, la próstata, el riñón, la tiroides, la retina y el hígado.
Ese enfoque es "un importante cambio de paradigma en términos de estudiar tejidos humanos en lugar de los tejidos animales como substitutos ... es realmente espectacular", dice Arnold Kriegstein, que estudia el cerebro en la Universidad de California en San Francisco.
Los organoides "van a tener un gran impacto en el entendimiento de las enfermedades, y también del desarrollo humano", dijo.